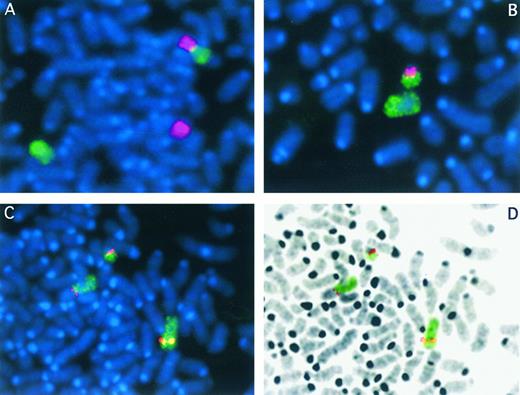
Fig. 1. FISH analysis of the t(8; 13) chromosome translocation from R.B. Somatic cell hybrids RBF1 (A) and RBF24 (B) were stained with DAPI (blue) in each case. Partial metaphase spreads are shown in each case after chromosome painting. The green signal represents chromosome 8 material, and the red signal is from chromosome 13. In RBF1 (A), the der(8) can be clearly seen (top), as can the normal copies of chromosomes 8 (green) and 13 (red). In hybrid RBF1 (B), only the normal 8 is seen, as well as the der(13). When YAC 959A4 from chromosome 8 is hybridized to cells from RBF1 (C) and then cells are identified that contain both of the derivative chromosomes, the hybridization signal from the YAC is seen (red) on the normal copy of chromosome 8 (bottom right), as well as the 2 derivative chromosomes (top left). In these cells, chromosome 8 material is painted green. The DAPI image from the partial metaphase chromosome spread shown in C has been processed in D to reveal the typical G-band appearance of the chromosomes. The derivative chromosomes therefore can be clearly identified. The red and green signals have been superimposed on this black and white image.

Abstract
A reciprocal chromosome translocation between 13q12 and 8p11 is the consistent cytogenetic abnormality seen in a nonspecific myeloproliferative disorder that is associated with T-cell leukemia/lymphoma and peripheral blood eosinophilia. Detailed molecular analyses of the translocation breakpoints associated with this rearrangement have not been reported to date. We have now generated somatic cell hybrids from a newly described patient with this specific structural rearrangement and analyzed the breakpoints on the derivative chromosomes. We have shown that the breakpoint on chromosome 13 lies within a 300- to 500-kb region defined by the KIAA177 gene and D13S1123 marker. In addition, we have identified a 1.2-Mb YAC, 959A4, that crosses the translocation breakpoint on the short arm of chromosome 8 in this patient. The location of this breakpoint in 8p11 is distinct from the t(8; 16) and t(8; 22) translocations associated with M4/M5 myeloid leukemias, and suggests that three distinct loci located within 8p11 are involved in the pathogenesis of myeloid neoplasias.
CHRONIC MYELOPROLIFERATIVE disorders (CMPDs) are hematopoietic neoplasms that specifically involve proliferation of myeloid precursors in the bone marrow. Each CMPD is identified by a characteristic expansion of a subset of myeloid cell lineages, dependent on the level of commitment reached by the original stem cell before transformation. Nonspecific myeloproliferative disorders show phenotypes that overlap with classic CMPDs, but are sufficiently dissimilar to be diagnosed as distinct clinicopathologic entities. The CMPDs are typically classified into four main categories: chronic myelogenous leukemia, polycythemia vera, agnogenic myeloid metaplasia, and essential thrombocythemia.
Abruzzo et al1 were the first to describe an atypical CMPD that is associated with T-cell leukemia/lymphoma and peripheral blood eosinophilia. Seven phenotypically related cases have now been described.1-5 The clinical course of the disease is particularly aggressive, with rapid progression of the malignancy to acute myelogenous leukemia or stem cell leukemia typically within 1 year of diagnosis. Indeed, three of these patients died within 16 months of initial presentation despite intensive chemotherapy and bone marrow transplantation. The initial clinical presentation of each of these cases is typified by generalized lymphadenopathy without mediastinal mass, leukocytosis, and peripheral eosinophilia in the absence of basophilia. In one patient, analysis of peripheral blood cell samples demonstrated germline configuration of T-cell receptor and Ig clusters suggestive of an atypical myeloproliferative disorder.5 Histologic and immunophenotypic analysis of lymph node biopsies also identified immature lymphoblastic cells of T-cell origin with variable infiltration of immature myeloblasts and mature eosinophils. Similar pronounced eosinophilia together with myeloid hyperplasia was noted within bone marrow aspirates. The diagnosis of a myeloproliferative disorder associated with lymphadenopathy is rare, and the involvement of neoplastic cells of both lymphoid and myeloid lineages suggests that the initiating event arose within a multipotent hematopoietic precursor.
Cytogenetic analysis of bone marrow aspirates taken from seven of the patients with the clinical phenotype already described revealed an almost complete replacement of normal bone marrow cells with leukemic cells carrying a translocation between 8p11 and 13q12 as the only cytogenetic abnormality. In one case, cytogenetic analysis was also performed on a lymph node biopsy, revealing the same translocation in the leukemic cells.3 This chromosomal rearrangement has not been noted in other hematologic malignancies and may therefore be characteristic of a subset of distinctive biphenotypic tumors. A tumor sample has now been obtained from a previously undocumented patient diagnosed with the same disease and carrying the same t(8; 13) translocation. It is notoriously difficult to selectively maintain leukemic cells in culture, and stimulation of bone marrow aspirates with mitogens prior to Epstein-Barr virus–induced transformation tends to lead to a preferential expansion of normal blood cells. Hence, to preserve this sample for further molecular analysis, we generated somatic cell hybrids from these tumor cells to “immortalize” the derivative chromosomes.
We have previously reported the molecular analysis of the t(8; 13) translocation from the archival tissue of two deceased patients with the atypical myeloproliferative disorder, T-cell leukemia and peripheral eosinophilia.6 Using fluorescence in situ hybridization (FISH), we identified a CEPH mega YAC, 943E4, that crosses the specific breakpoint in 13q12.1, localizing the breakpoint to a 1.9-Mb region of DNA close to the AFM microsatellite markers D13S283 and D13S221. Physical maps of the 13q12 region have now been determined that describe the precise order and physical localization of ESTs and genes mapped to this area.7,8 We now present the refinement of the localization of the translocation breakpoint on chromosome 13 relative to this framework of markers based on the analysis of these somatic cell hybrids. However, similar analysis of the translocation breakpoint in 8p11 has not previously been performed. However, we now report the localization of the translocation breakpoint in 8p11 using FISH analysis and YACs that have been mapped to this region.
MATERIALS AND METHODS
Cell culture.Somatic cell hybrids were prepared using polyethylene glycol (PEG) as described previously.9 All hybrid cell lines were grown in minimal essential medium supplemented with 10% fetal bovine serum and 2 mmol/L glutamine. Cells were harvested and transferred using trypsin/EDTA. DNA from hybrids for polymerase chain reaction (PCR) analysis was prepared from a single 9-cm petri dish as described by Hawthorn and Cowell.10
PCR analysis of somatic cell hybrids.PCR assays were performed using 100 ng somatic cell hybrid DNA, 0.5 μmol/L of each primer, 2.0 mm MgCl2 , 50 mm KCl, 20 mm Tris HCl (pH 8.8 at 25°C), 250 μm of each dNTP, and 1 U Taq DNA polymerase. Samples were denatured at 94°C for 3 minutes followed by 40 cycles of denaturation at 94°C for 1 minute, annealing at 48°C for 1 minute, and extension at 72°C for 1 minute. Reactions were performed in an Ericomp thermocycler (Deltacycler II, Ericomp, San Diego, CA). Products were visualized on 3.5% agarose gels.
FISH.Metaphase chromosome spreads were prepared using standard air-drying techniques. FISH analysis was performed basically as described by Kempski et al.6 Total DNA from the yeast host cell containing the YAC of interest was labeled with biotin-14-dATP using the Bio-Nick kit (GIBCO Grand Island, NY) or digoxigenin-11-dUTP using the Dig-Nick kit (Boehringer, Mannheim, Germany).
RESULTS
A major problem with studying the t(8; 13) chromosome translocation in the past has been obtaining adequate fresh samples carrying the rearrangement. Most of the patients described in the literature are deceased because of the aggressive clinical course of the disease. This included two patients we reported previously,6 in which the only material available to us was archival, fixed chromosome preparations where there were insufficient metaphase spreads to analyze the breakpoint on chromosome 8 in any detail. The problem with collecting fresh samples is that by the time cytogenetic analysis has been completed, the patients are already receiving chemotherapy or are being prepared for a bone marrow transplant. The high mortality rate also often precludes obtaining repeat samples. Since these tumor cells are difficult to culture, obtaining a constant supply of the rearranged chromosomes is not possible. Because of this limitation, we decided to create somatic cell hybrids from fresh cells carrying the t(8; 13) rearrangement and thereby immortalize the derivative chromosomes for future study.
Case report.R.B. was a 29-year-old man who originally presented in February 1993 with fevers, chills, night sweats, nausea, diarrhea, and lymphadenopathy. A chest x-ray showed mediastinal and hilar adenopathy. This was confirmed by computed tomographic scans that also showed generalized lymphadenopathy in the abdomen along with moderate splenomegaly. Laboratory studies included a white blood cell (WBC) count of 3,900/μL, hemoglobin and hematocrit levels of 18.6 g/dL and 52.9%, and a platelet count of 120,000/μL. The differential included 60% neutrophils, 11% lymphocytes, 11% eosinophils, and 7% monocytes. A lymph node biopsy was read as lymphoblastic lymphoma with phenotypic markers consistent with a T-cell neoplasm. A bone marrow biopsy and aspirate was hypercellular with marked granulocytosis. No excess blasts were noted. Cytogenetic analysis of the bone marrow was interpreted as 46,XY,t(8; 13)(p11.2;q12). The patient was treated with a regimen for lymphoblastic lymphoma, but he had a relapse in September 1995 and was referred for an allogeneic bone marrow transplant. At the time of relapse, the WBC count was 18,500/μL with 5% neutrophils, 30% lymphocytes, 2% monocytes, and 58% blasts. A bone marrow biopsy and aspirate showed a hypercellular marrow with 87% blasts that expressed rare PAS positivity. The myeloperoxidase stain was negative. Flow cytometry showed the blasts to be consistent with a pre-B cell ALL that was CD34+, CD38+, HLA-DR+ CD19+, and CD10+. All T-cell markers tested were negative. Cytogenetic analysis showed a single abnormal clonal cell line in all of the 20 metaphases analyzed: 48,XY,+8, t(8; 13)(p11;q12), +21. The patient underwent reinduction therapy with cyclophosphamide, vincristine, methotrexate, prednisone, and doxorubicin. A repeat bone marrow showed decreased cellularity with 22% blasts, with cytogenetic findings interpreted as 48,XY, +8, t(8; 13) (p11;q12), +21. He was then treated with high-dose cytarabine and L-asparaginase, but failed to achieve a complete response. He underwent a matched unrelated allogeneic bone marrow transplant in February 1995 for persistent disease. Cytogenetic analyses on the pretransplant marrow showed 48,X, add (Y)(q11), +8, t(8; 13)(p11;q12), +21. Unfortunately, the patient died on day +33 with pulmonary aspergillosis and pulmonary hemorrhage.
Generation of somatic cell hybrids.Cytogenetic analysis of tumor tissue obtained by bone marrow aspiration showed complete replacement with a single leukemic clone carrying a t(8; 13)(p11;q12) translocation. Approximately 107 tumor cells were fused with 5 × 106 murine 3T3 tk− cells using PEG as described by Cowell.9 Since bone marrow cells do not attach to the surface of culture dishes, no selective pressure was required against the human cells. Following PEG fusion and HAT selection to eliminate parental mouse cells, individual colonies were isolated using ring cloning,9 and these cells were grown for PCR and cytogenetic analysis.
Initially, cells from 72 clones were analyzed using the D8S257 marker from 8q22.1 (distal) and an EST from the defensin gene in 8p21 (proximal) that lay on either side of the 8p11 breakpoint. Similarly, D13S183E and D13S505E were used as markers that lay proximal and distal to the 13q12 breakpoint, respectively. PCR analysis using these markers identified a single hybrid, RBF24, that carried only D13S183E, suggesting the presence of the derivative chromosome 13 in the absence of the normal chromosome 13. Unfortunately, this hybrid and all other hybrids tested positive for chromosome 8–specific markers, indicating that each hybrid had retained the normal copy of chromosome 8.
FISH analysis of hybrids.Hybrid colonies isolated by ring cloning9 usually demonstrate considerable heterogeneity in terms of the human chromosome component. Thus, by using PCR analysis of DNA from these colonies, a positive signal will be detected even when only a small percentage of the cells contain the chromosome of interest. PCR analysis is also unable to detect the presence of a rearranged chromosome in the presence of its normal homolog. Hence, to identify a hybrid with the derivative chromosome 8, we used chromosome 13– and 8–specific paints to analyze these hybrids further.
PCR analysis indicated that the RBF24 hybrid contained the derivative chromosome 13, and this was confirmed using FISH (Fig 1). In fact, this hybrid appeared stable with respect to the human chromosome content: all cells analyzed contained both the derivative chromosome 13 and an apparently normal copy of chromosome 8. Systematic FISH analysis of the other hybrids led to the identification of one, RBF1, that, although retaining a normal copy of chromosome 8, also contained the derivative chromosome 8. Some of the cells in this hybrid also contained the derivative chromosome 13 and a normal copy of chromosome 13. Although this hybrid was of limited use for PCR analysis, it provided a means of studying the breakpoints on the two derivative chromosomes using FISH, often in the same cell.
FISH analysis of the t(8; 13) chromosome translocation from R.B. Somatic cell hybrids RBF1 (A) and RBF24 (B) were stained with DAPI (blue) in each case. Partial metaphase spreads are shown in each case after chromosome painting. The green signal represents chromosome 8 material, and the red signal is from chromosome 13. In RBF1 (A), the der(8) can be clearly seen (top), as can the normal copies of chromosomes 8 (green) and 13 (red). In hybrid RBF1 (B), only the normal 8 is seen, as well as the der(13). When YAC 959A4 from chromosome 8 is hybridized to cells from RBF1 (C) and then cells are identified that contain both of the derivative chromosomes, the hybridization signal from the YAC is seen (red) on the normal copy of chromosome 8 (bottom right), as well as the 2 derivative chromosomes (top left). In these cells, chromosome 8 material is painted green. The DAPI image from the partial metaphase chromosome spread shown in C has been processed in D to reveal the typical G-band appearance of the chromosomes. The derivative chromosomes therefore can be clearly identified. The red and green signals have been superimposed on this black and white image.
FISH analysis of the t(8; 13) chromosome translocation from R.B. Somatic cell hybrids RBF1 (A) and RBF24 (B) were stained with DAPI (blue) in each case. Partial metaphase spreads are shown in each case after chromosome painting. The green signal represents chromosome 8 material, and the red signal is from chromosome 13. In RBF1 (A), the der(8) can be clearly seen (top), as can the normal copies of chromosomes 8 (green) and 13 (red). In hybrid RBF1 (B), only the normal 8 is seen, as well as the der(13). When YAC 959A4 from chromosome 8 is hybridized to cells from RBF1 (C) and then cells are identified that contain both of the derivative chromosomes, the hybridization signal from the YAC is seen (red) on the normal copy of chromosome 8 (bottom right), as well as the 2 derivative chromosomes (top left). In these cells, chromosome 8 material is painted green. The DAPI image from the partial metaphase chromosome spread shown in C has been processed in D to reveal the typical G-band appearance of the chromosomes. The derivative chromosomes therefore can be clearly identified. The red and green signals have been superimposed on this black and white image.
Characterization of the chromosome 13 translocation breakpoint.The availability of hybrid RBF24 meant that we could characterize the position of the breakpoint on chromosome 13 at the molecular level. We have previously shown that the CEPH mega YAC 943E4 crosses the translocation breakpoint in tumor samples from two patients with a similar t(8; 13) translocation.6 To date, seven genes and two AFM microsatellite markers have been mapped within this 1.9-Mb region.7-8, 11-12 Furthermore, a recent report7 indicated that a deletion had occurred during cloning of the 943E4 YAC, since this group identified three additional markers from this region (D13S1123, D13S1115, and D13S292) that were not present in 943E4 (Fig 2). To characterize the site of the 13q12 breakpoint in R.B., we used PCR to establish the presence/absence of these markers in the somatic cell hybrid RBF24 that contains the derivative chromosome 13 (as already noted). Markers D13S1122 and KIAA177 were present in this hybrid. However, all of the markers distal to and including D13S1123 were absent from the hybrid. Thus, according to the map presented by Guilford et al7 and extended by Still et al,8 the translocation breakpoint on chromosome 13 lies between KIAA177 and D13S1123 (Fig 2). From the current physical mapping data,7,8 we estimate the size of this region to be between 300 and 500 kb.
Summary of the physical map in 13q12 encompassing the 8; 13 translocation breakpoint. The relative positions of the markers in YAC 943E4 are shown based on reports by Guilford et al7 and Still et al.8 The YAC is indicated by the horizontal bar, and the physical map relative to the breakpoint region is shown above. The thin horizontal line within the YAC indicates the presence of a deletion based on the absence of markers as determined by PCR. The map is oriented relative to the 13 centromere (cen) and the long arm telomere (qter). The 8; 13 translocation breakpoint lies between KIAA177 and D13S1123 as determined by somatic cell hybrid analysis.
Summary of the physical map in 13q12 encompassing the 8; 13 translocation breakpoint. The relative positions of the markers in YAC 943E4 are shown based on reports by Guilford et al7 and Still et al.8 The YAC is indicated by the horizontal bar, and the physical map relative to the breakpoint region is shown above. The thin horizontal line within the YAC indicates the presence of a deletion based on the absence of markers as determined by PCR. The map is oriented relative to the 13 centromere (cen) and the long arm telomere (qter). The 8; 13 translocation breakpoint lies between KIAA177 and D13S1123 as determined by somatic cell hybrid analysis.
Characterization of the chromosome 8 translocation breakpoint.Due to the presence of a normal chromosome 8 in all the hybrids tested, we were unable to perform a similar PCR-based analysis to localize the site of the translocation breakpoint on chromosome 8. The approach we have taken to define this breakpoint is therefore to use nonchimeric CEPH megaYACs derived from the 8p11 region13 and to analyze cells from somatic cell hybrid RBF1 that contain both of the derivative chromosomes. A summary of the physical map and the YACs that span this region is shown in Fig 3. Recently, analysis of the t(8; 22)(p11;q13) breakpoint seen in acute monocytic leukemia14 using FISH indicated that the chromosome 8 breakpoint lay within a 1,030-kb region defined by the CEPH megaYAC 782H11 (Fig 3). When YAC 782H11 was hybridized to the chromosomes from RBF1, it hybridized exclusively to the derivative chromosome 8. However, when YAC 959A4, which overlaps with 782H11, was used, hybridization was seen on both derivative chromosomes, demonstrating that this YAC crosses the t(8; 13) breakpoint (Fig 1). Thus, we have been able to show with this analysis that the 8p11 translocation breakpoint in t(8; 13)-containing tumors lies in a different position than the t(8; 22) breakpoint.
Summary of the physical map in 8p11 encompassing the 8; 13 translocation breakpoint.The position of genetic markers from the physical map relative to the chromosome 8 centromere (cen) and telomere of the short arm (pter) are shown at the top. The presence of these markers (indicated by the vertical lines) in a series of YACs (indicated by the horizontal bars) is shown. Since there are no markers linking YACs 782H11 and 910D7, the distance between the ends of these YACs could not be determined. The 8; 13 translocation breakpoint lies in the interval between the ends of YACs 676A7 and 782H11.
Summary of the physical map in 8p11 encompassing the 8; 13 translocation breakpoint.The position of genetic markers from the physical map relative to the chromosome 8 centromere (cen) and telomere of the short arm (pter) are shown at the top. The presence of these markers (indicated by the vertical lines) in a series of YACs (indicated by the horizontal bars) is shown. Since there are no markers linking YACs 782H11 and 910D7, the distance between the ends of these YACs could not be determined. The 8; 13 translocation breakpoint lies in the interval between the ends of YACs 676A7 and 782H11.
Because of the considerable interest in 8p11 in leukemias, the physical contig map data for this region are relatively complete and are summarized in Fig 3. The overlap between three of the YACs described in this figure has been determined by restriction mapping and the presence of the FGF receptor gene13 in all three of these YACs. FISH analysis using YAC 676A7, which contains the FGF receptor gene, demonstrates that it does not cross the 8; 13 breakpoint. Thus, based on the size of YACs in this contig and their relative degree of overlap, we estimate that the 8; 13 breakpoint lies within a 300-kb region between the ends of YACs 676A7 and 782H11.
DISCUSSION
Structural rearrangements involving chromosome 13 have been implicated in a variety of different myeloproliferative and myelodysplastic disorders.15-19 In this report, we have localized the translocation breakpoint in 13q12 associated with a biphenotypic atypical myeloproliferative disorder to a 300- to 500-kb region encompassed by the two markers KIAA177 and D13S1123. Determining whether the genes involved in rearrangements involving 13q12 in all CMPDs also lay in this region awaits either cloning of this gene or characterization of the position of the breakpoints in the other variant CMPDs.
Acquisition of an additional chromosome 8 is seen as a secondary change in a number of different hematologic malignancies.20 In a series of 3,996 patients with discernible chromosomal abnormalities, evidence of an extra chromosome 8 was observed in approximately 10% of cases. Trisomy 8 is strongly associated with polycythemia vera both at presentation and during progression.21 Reciprocal translocations involving the short arm of chromosome 8 have also been recognized as a primary event in myeloid leukemias. Rearrangements of the short arm of chromosome 8 are typically associated with reciprocal translocations between 8p11 and either 9q32-3422-23 or 16p13.24-26 A variant translocation between 8p11 and 22q13 has also been identified.18 The consistent feature of these translocations is their involvement in monocytic lineages with varying degrees of differentiated elements. Indeed, Lai et al27 noted that in a series of leukemic patients translocations involving 8p11 constituted 6.5% of cases with M4 or M5 acute myeloid leukemias. This would indicate that a gene involved in the differentiation of monocytes resides at the location of the translocation breakpoint on chromosome 8. In addition, eosinophilia is a specific symptom of the t(8; 9) translocation, with eosinophils comprising up to 50% of granulocytes in the bone marrow of these patients.23 The clinical course of the disease associated with these translocations is typically poor, with death occurring within 14 months after initial presentation.22,23
The pericentromeric short arm region of chromosome 8 is frequently involved in structural chromosome rearrangements in myeloid leukemias, primarily of monocytic origin. Recently, the translocation breakpoints associated with t(8; 16)(p11;p13) seen in M4/M5 myelomonocytic leukemia were identified by positional cloning.28 This led to identification of a putative chromatin-associated acetyltransferase gene, MOZ, at the site of the translocation breakpoint on 8p11, which raised the possibility that rearrangement of this gene was pivotal in the pathogenesis of leukemias with translocation breakpoints within 8p11.28 The MOZ gene is present in YAC 910D7. However, this YAC has been shown by FISH analysis to be located centromeric to the t(8; 22)(p11;q13) breakpoint seen in acute monocytic leukemia14 and therefore is not involved in the t(8; 13) rearrangement. In turn, the 8; 22 translocation breakpoint was shown to be within a 1,030-kb region defined by the CEPH mega YAC 782H11. In our patient, YAC 782H11 hybridized exclusively to the derivative chromosome 8. However, when YAC 959A4, which overlaps with 782H11, was used, hybridization was seen on both derivative chromosomes, demonstrating that this YAC crosses the t(8; 13) breakpoint. YAC 910D7, which contains the MOZ gene, is located centromeric to 782H11 and this region and so is clearly not involved in the t(8; 13) breakpoint. Thus, we have been able to show with this analysis that the 8p11 translocation breakpoint in t(8; 13) tumors does not involve the MOZ locus associated with the t(8; 16) translocation and also lies in a different position compared with the t(8; 22) breakpoint. These studies clearly indicate that three different genes involved in the pathogenesis of leukemias of myeloid origin are located within the pericentromeric short arm of chromosome 8.
Using the somatic cell hybrids thus generated, we are now in a position to further refine the location of the translocation breakpoints on both derivative chromosomes. This will permit us to isolate and assess candidate genes from the regions encompassing both translocation breakpoints. It is likely that the genes located at the translocation breakpoints on both chromosomes 8 and 13 play crucial roles in the control of hematopoiesis. The mixed cell lineage of the neoplasia associated with the t(8; 13) translocation suggests that the primary genetic event leading to tumorigenesis arose within a multipotent stem cell capable of differentiation into both myeloid and lymphoid cells. Therefore, the cloning of these genes will shed light on important aspects of the control of proliferation and differentiation of hematopoietic stem cells and the underlying mechanism in the pathogenesis of this unusual biphenotypic tumor.
Address reprint requests to John K. Cowell, PhD, Department of Neurosciences NC30, Research Institute, Cleveland Clinic Foundation, 9500 Euclid Ave, Cleveland, OH 44195.